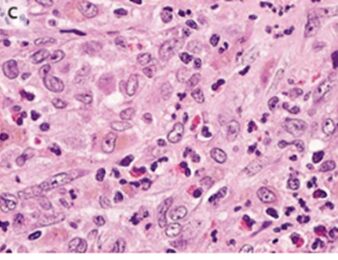

- 2025年11月6日
- 2025年12月22日
肺ランゲルハンス細胞組織球症:2週間続く咳嗽、呼吸困難、寝汗、胸膜炎による左側胸痛を主訴にX-p施行し、TBLBで確定診断です。PSLと禁煙が重要です。
40歳男性。喫煙歴あり。
2週間前から咳嗽、呼吸困難、寝汗、胸膜炎による左側胸痛のため外来を受診した。
聴診では左肺野の呼吸音が減弱していた。
胸部X-pでは左肺に気胸と両肺の透過性低下を認めた(A)。
胸腔ドレーン挿入後の胸部CTでは主に上肺野と中肺野に複数の嚢胞と結節が示唆され、肋横隔角は温存されていた(B)

確定診断のために経気管支肺生検(TBLB)が施行された。
組織病理学的検査では、肺胞間中隔肥厚を伴うリンパ球性肺浸潤、好酸球、法膜状の細胞質および巨大核を有する大型細胞を認めた。
免疫組織化学染色ではS-100タンパク質、CD1a、胎盤酸性ホスファターゼ、ランゲリンが陽性だった。
「肺ランゲルハンス細胞組織球症」と診断された。
追加検査では全身性組織球症は認めなかった。
患者は禁煙するよう勧められ、またPSLが開始された。
6か月のフォローでは禁煙を継続し、PSLは低用量まで漸減できており、症状もわずかに残存している程度だった。
N Engl J Med 2022; 387:2449
DOI: 10.1056/NEJMicm2203885
柏五味歯科内科リウマチクリニック
ホームページ